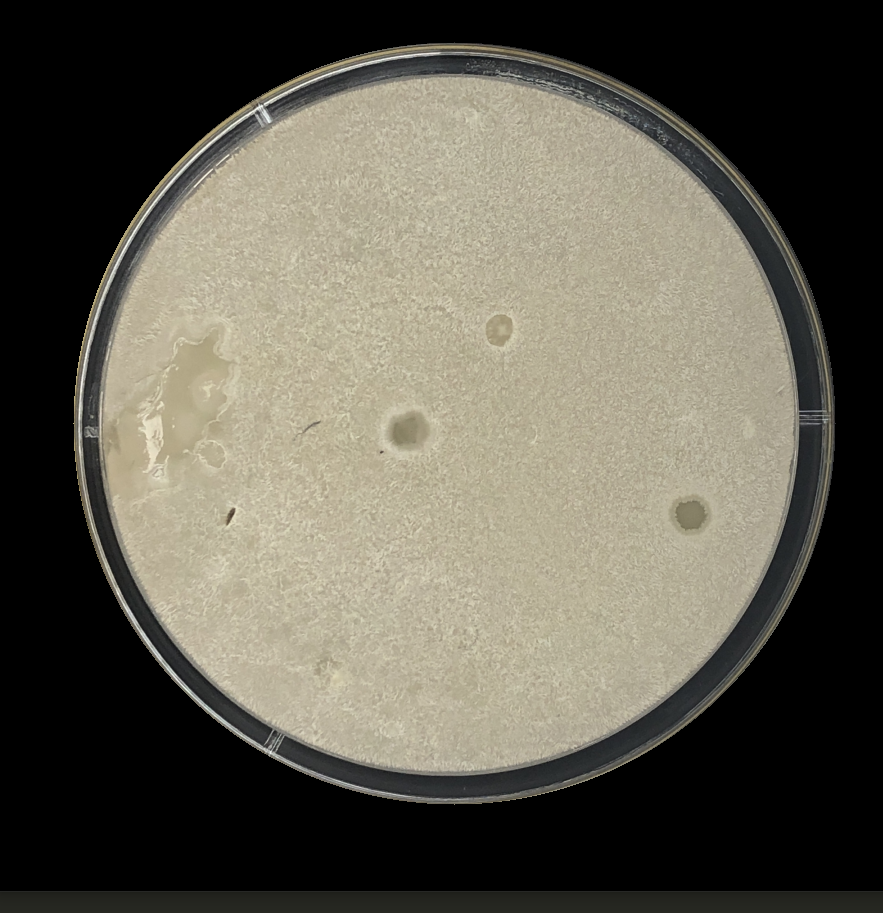
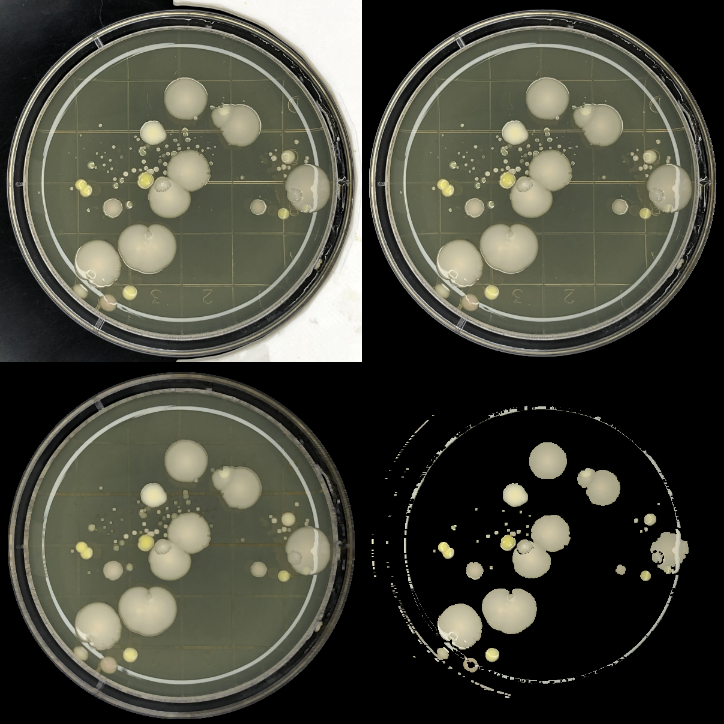
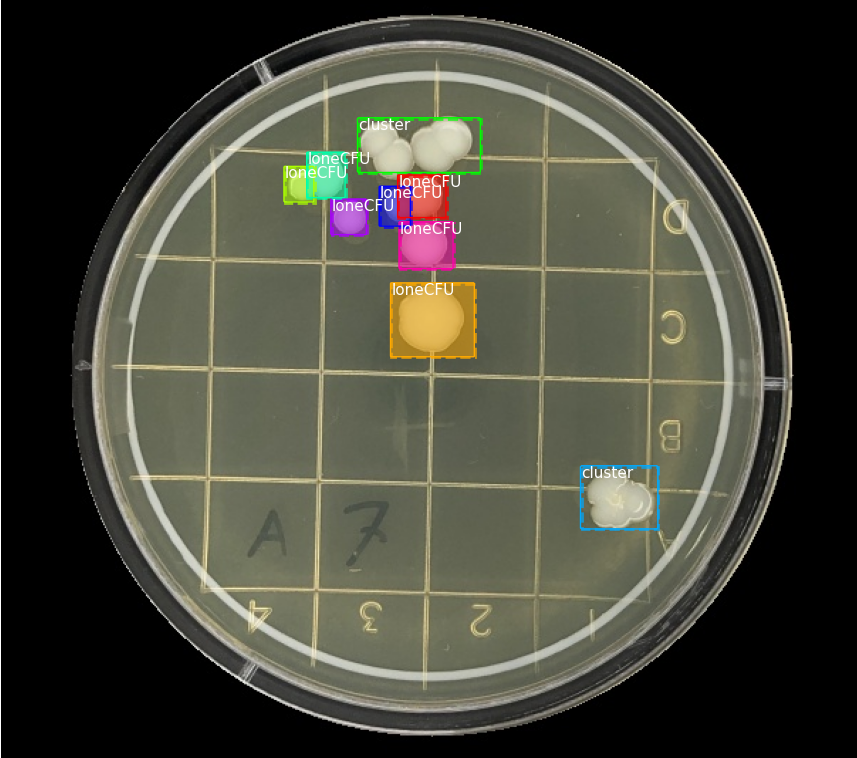

Laidlaw Research: OpenCV and Deep learning
Week 3: Utilising better Pre-processing Methods

I also tried fixing up the contact plate, blurring any drawn lines that were present in the image. However, I discovered that there was data being lost due to the blurring algorithm. Notice how the smaller CFUs are being lost after processing.
Week 4: Colony Object Detection
Week 4 started with the meeting with my supervisor's colleague. We talked about what I have done so far with fast.ai and the dataset that was available to me. We then decided on identifying individual CFUs using object detection. Object detection can be seen as a subset of deep learning, with the following steps:
-
Image classification: What is in this image?
-
Object localization: Where are the "objects" in this image/creating bounding boxes.
-
Object detection: Identity what each "object" in the image is.
We found this to be the best approach as it shouldn't rely on the quality of the threshold mask since it doesn't need one at all. The only problem is, the best way to do object detection was through Keras since that was the program they were most familiar with and could help me with. No matter though, I'm always up to learning new things (famous last words).
Oh! And, I also got to control some robots too which was pretty cool!

So that's it for my update blog! Again, I hope you all enjoyed the read! To be honest I'm starting to feel the pressure with this research. I'm essentially learning as I go regarding deep learning, but it's very rewarding when stuff works. I'm also a bit more confident with my communication and networking after that meeting, so that's a plus!
Remember, if you want to keep up to date, follow my Instagram, @joeceengineering!
Until next time, thanks again for reading!
Please sign in
If you are a registered user on Laidlaw Scholars Network, please sign in